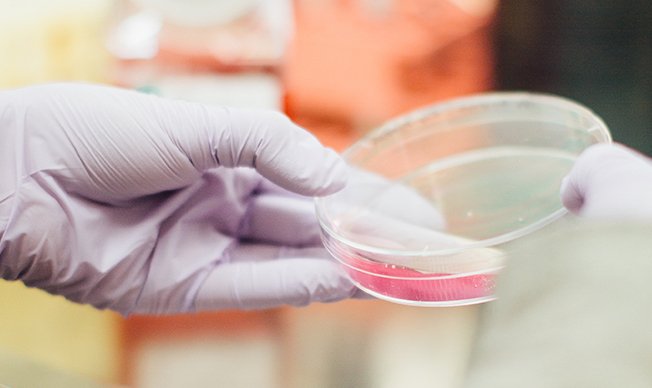

List of collections
Products
-
MODEL: G380-8021
-
MODEL: C8700-820
-
MODEL: M250-2104
100X DIN ACHROMAT OBJECTIVE, N.A. 1.25, OIL, RETRACTABLE FRONT LENS
-
MODEL: M280-2104
100X DIN ACHROMAT OBJECTIVE, N.A. 1.25, OIL, RETRACTABLE FRONT LENS
-
-
MODEL: IP730-2104
100X DIN ACHROMAT OBJECTIVE, N.A. 1.25, RETRACTABLE FRONT LENS
-
MODEL: G380-2304
-
-
MODEL: IP750-2104
100X INFINITY ACHROMATIC OBJECTIVE FOR IP750 INFINITY MICROSCOPE
-
MODEL: IP750-2304
100X INFINITY PLAN ACHROMATIC OBJECTIVE FOR IP750 INFINITY MICROSCOPE
-
MODEL: G380-2604
-
MODEL: G380-2634
100X OIL IMMERSION INFINITY PLAN ACHROMAT OBJECTIVE, NA 1.25
-
MODEL: G500-2304
-
MODEL: G500-2434
-
MODEL: C800-05
-
MODEL: G500-2102
-
MODEL: M250-2102
-
MODEL: M280-2102
-
MODEL: IP730-2102
-
MODEL: G380-2102
-
MODEL: G380-2302
-
MODEL: G380-2202
-
MODEL: G500-1402
-
MODEL: G500-1404

Best tools for the Medical office
Top Selection
-
MODEL: G380-8021
-
MODEL: C8700-820
-
MODEL: M250-2104
100X DIN ACHROMAT OBJECTIVE, N.A. 1.25, OIL, RETRACTABLE FRONT LENS
-
MODEL: M280-2104
100X DIN ACHROMAT OBJECTIVE, N.A. 1.25, OIL, RETRACTABLE FRONT LENS








































